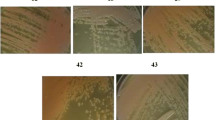

Abstract
Seven metal-resistant yeast strains were isolated and selected from Dayet Oum Ghellaz Lake water (northwest of Algeria) known as a highly polluted area by lead and cadmium. The yeast strains were screened on the basis of their resistance to seven heavy metals Hg, Cr, Cd, Pb, Cu, Zn, and Fe and characterized by molecular and phylogenetic analysis. The sequencing of the D1/D2 domain of the 26S rRNA genes revealed the affiliation of the seven yeast isolates to Rhodotorula mucilaginosa, Clavispora lusitaniae, and Wickerhamomyces anomalus species. All yeast strains were halotolerant as they were able to grow in 10–15% NaCl. The yeast isolates were highly resistant to the studied heavy metals and exhibited different tolerance according to the metal type. The highest minimum inhibitory concentrations (MIC) were observed in R. mucilaginosa RO7 and W. anomalus WO2 strains which were then selected for lead removal assays. The present study is the first to investigate the lead elimination by W. anomalus. The lead uptake was significantly affected by biomass concentration in a reverse relationship, with purification percentages estimated at 98.15 ± 0.9% and 97.046 ± 0.47% and removal efficiency of 12.68 ± 0.91 and 15.55 ± 0.72 mg/g for W. anomalus WO2 and R. mucilaginosa RO7, respectively. The investigated metal-tolerant yeast strains proved to be promising candidates for bioremediation processes of heavy metals. This work amends the metal-resistant yeast bank with new strains having interesting abilities to resist to relatively high concentrations of toxic heavy metals and which can be used in the near future as low-cost biosorbents.
Similar content being viewed by others
Explore related subjects
Discover the latest articles, news and stories from top researchers in related subjects.Avoid common mistakes on your manuscript.
Introduction
Heavy metals released into the environment can be resulted from natural sources or human industrial and agricultural activities, including discharges of pesticides and phosphate fertilizers (El-Shahawi et al. 2010; Lepp 2012). As a result, metals can widely diffuse in all environmental compartments (soil, water, air, and their interface) and lead consequently to serious environmental pollution especially in the case of water, as all the worldwide populations rely on groundwater for drinking and irrigation. Most of heavy metals become toxic, even at low concentrations, and hence, when present in environment, they enter food chain, thereby causing harmful effect to human and animal health. Moreover, the toxicity of heavy metals, including lead, is strongly dependent on the amount available to organisms, the absorbed dose, the time, and the route of exposure (Mani and Kumar 2014). Heavy metals are difficult to remediate through physical and chemical methods due to many disadvantages, including high costs, high energy, and generation of high quantity of chemical wastes (Ayangbenro and Babalola 2017). So far, the use of some yeast indices, like yeast biomasses, is proved as an efficient alternative tool in remediation of heavy metal-contaminated environments (Sun et al. 2020). Noteworthy, a long-term exposure of microorganisms to high metal concentrations develops their resistance capacity, and thus, when present in contaminated soils and wastewaters, they become a biological source for metal removal (Parameswari et al. 2010; Rigoletto et al. 2020). Further, microorganisms have developed strategies for continued existence in heavy metal-contaminated environments by means of various biological mechanisms, such as bioaccumulation, biomineralization, biosorption, and biotransformation (Melgar et al. 2007; Ayangbenro and Bobalola 2017; Tarekegn et al. 2020), contributing effectively in heavy metal removal and recovery of polluted environments. The bioremediation of water has become a major concern in the world and highlighted the strong need for the development of efficient microbiological and microbial ecological approaches and encouraged selection of alternative remedies. The omnipresence of yeasts in several natural ecosystems and their exposure to a variety of extreme conditions induced stress responses which accentuated their defense mechanisms. Considering the ecological benevolence of microorganisms for bioremediation of heavy metals, the present study was conducted in order to identify and characterize metal-resistant yeast strains isolated from polluted lake in the northwest of Algeria. The yeast strains exhibiting desirable heavy metal degradative qualities will be a promising microbiological tool for in situ bioremediation operations of natural contaminated water and industrial effluent.
Materials and methods
Sample collection and water physicochemical analysis
In the present study, the water samples analyzed were collected from Dayet Oum Ghellaz, a lake located in Oran city (northwest of Algeria, 35°36′08.0″N 0°25′22.8″W, study area of 300 ha, a maximum altitude of 125 m), at 12 km from Hassi Amer industrial zone II. The lake is characterized by temperature ranging between 9 and 32 °C and an annual mean precipitation of 350 mm. Samples were taken from five randomly chosen places on the surface of the lake at 0.5–1 m of depth and during four seasons (autumn, winter, spring, and summer). The water samples were aseptically collected in sterilized flasks and transported on ice (4 °C) to the laboratory for the analyses of the following physicochemical parameters: pH, electric conductivity, phosphate, biochemical oxygen demand in 5 days (BOD5), chemical oxygen demand (COD), the ratio COD/BOD5, and some heavy metals, like chromium (Cr), cadmium (Cd), copper (Cu), zinc (Zn), iron (Fe), and lead (Pb). To assess the quality of lake water content of heavy metals, the metal index (MI) was employed (Tamasi and Cini 2004). This index is calculated by the ratio of heavy metal content in the water (ppm) based on the corresponding values (in Bendjama et al. 2014), where MI > 1 indicates that the water is polluted.
Yeast isolation
The cultivable yeasts were isolated from the sampled water of Dayet Oum Ghellaz Lake using yeast extract peptone dextrose agar plates (YPD medium) containing 0.5% w/v yeast extract, 1% w/v peptone, 2% w/v glucose, and 2% w/v agar. One hundred microliters of water samples were aseptically plated on YPD agar and incubated for at least 3 days at 28 °C. The colonies presenting the typical yeast morphotypes were then picked up and purified by repeated streaking on fresh YPD agar plates. After the purity control, the isolated yeasts were stored at − 20 °C in YPD broth supplemented with glycerol (30% v/v final concentration) (Villegas et al. 2004).
Semiquantitative screening for heavy metal resistance and salt tolerance
The agar well diffusion assay was used to test the resistance of the isolated yeast strains (Gadd et al. 1986) against seven selected soluble heavy metals (CdCl2, ZnSO4, Pb(NO3)2, K2CrO4, CuSO4, HgCl2, and FeCl3). Wells of approximately 6-mm diameter were created in YPD agar plates previously inoculated with 100 µl of yeast strain suspensions. Agar wells were then filled with 40 µl aliquots of heavy metal solutions with various concentrations (10, 25, 50, 100, 150, and 200 mM) prepared by dissolving the appropriate quantities in bi-distilled water followed by a sterilization cycle at 120 °C for 20 min (Benmalek and Fardeau 2016). The inhibition zone diameter was determined after incubation of strains at 28 °C during 72 h. Wells filled with sterilized distilled water were used as controls. Thus, yeast strain is considered as tolerant to the corresponding heavy metal when their inhibition zone diameter is equal or lower than 10 mm. Yeast strains resistant to the studied heavy metals were selected and subjected to molecular identification and evaluation of MIC.
Halotolerance of yeasts was measured by analyses of growth capacity under various concentrations of NaCl. Each yeast strain was streaked onto YPD solid medium containing different concentrations of sodium chloride (0%, 3%, 5%, 10%, 15%, 20% (w/v)) and incubated at 28 °C for 72 h.
DNA extraction, PCR amplification, and sequencing
The yeast genomic DNA was extracted and amplified at the Biological Resource Center CIRM-Levures, Micalis Institute, INRA/AgroParisTech, France following the procedures described by Hoffman and Winston (1987) and Burgaud et al. (2016), respectively. For the DNA isolation, 10 ml of the yeast cultures was grown until saturation. The yeast cells were then collected by centrifugation and resuspended in 0.5 ml of water. The cells were additionally transferred to a new microfuge and pelleted by a 5-s centrifugation. After cell harvesting, the supernatant is decanted and the pellet is resuspended by brief vortexing in the residual liquid. 0.2 ml of 2% Triton X-100, 1% SDS, 100 mM NaCl, 10 mM Tris pH 8.0, and 1 mM EDTA are then added followed by the incorporation of 0.2 ml phenol–chloroform-isoamyl alcohol (25:24:1; the addition of isoamyl alcohol is optional). 0.3-g acid-washed glass beads (Thomas Scientific, Philadelphia, PA; 0.45–0.52-mm glass beads, solid, for cell homogenizers) are then needed. The glass beads are prepared by soaking in concentrated nitric acid for 1 h, washing extensively with water, and baking until dry. The solution is vortexed for 3 to 4 min followed by the addition of 0.2 ml TE. The microfuge is spun for 5 min and the aqueous layer is transferred to a new tube and mixed by inverting with 1.0 ml 100% ethanol. Another fast spin for 2 min is necessary before the resuspension of the pellet in 0.4 ml TE plus 30 µg RNase A (Sigma Chemical Co., St. Louis, MO) for 5 min at 37 °C. 10 µl of 4 M ammonium acetate plus 1.0 ml of 100% ethanol are then added and mixed by tube inverting. The pellet is finally spun for 2 min, dried, and resuspended in 50 µl TE. The amplification was performed on the D1/D2 domain of the LSU rRNA gene. The D1/D2 rRNA gene was symmetrically amplified by PCR using the universal fungal primers NL1 (5′-GCATATCAATAAGCGGAGGAA-3′) and NL4 (5′-GGTCCGTGTTTCAAGACGG-3′) (O’Donnell 1993). The PCR reaction mixture contained 1 U Takara ExTaq, 0.8 mM dNTPs, 0.4 μM forward and reverse primers in the recommended buffer, and 25–50 ng of template DNA in a final volume of 50 μl. Cycling conditions consisted in an initial denaturation step at 94 °C for 4 min, followed by 30 cycles of 30-s denaturation at 94 °C, 40-s annealing at 54 °C, and 90-s elongation at 72 °C, with a final extension step of 7 min at 72 °C. Successful amplification products were verified by electrophoresis using a 1% agarose gel. Sequencing reactions were performed on both strands with the corresponding primers (NL1 and NL4) by Eurofins MWG Operon (Ebersberg, Germany) at the Biological Resource Center CIRM-Levures (France).
Nucleotide sequence accession numbers
The nucleotide sequences of the selected yeast isolates generated in the present study were deposited in the NCBI GenBank database under accession numbers reported in Table 2.
Phylogenetic analysis
A search for homology among the D1/D2 domain from the LSU (26S) rDNA sequences was done using the BLAST algorithm (Altschul et al. 1997) available in public databases such as GenBank at the National Center for Biotechnology Information (NCBI), USA (http://www.ncbi.nlm.nih.gov) in order to determine the closest relatives and then aligned with them. The sequence alignments were performed using the MUSCLE algorithm in MEGA 7.0 software (Kumar et al. 2016) and were adjusted manually. Each DNA sequence was assembled and edited manually if needed. Phylogenetic trees were constructed on the final alignment using the maximum likelihood program implemented in MEGA 7.0 with 1000 bootstrap replications and Kimura two-parameter model with gamma distribution (K2 + G) (Kimura 1980). Confidence values were estimated from bootstrap analyses of 1000 replicates. Schizosaccharomyces pombe UCDFST 40–277 (MH595199) was used as outgroup species to root the tree.
Determination of minimum inhibitory concentration (MIC) of heavy metals
The yeast isolates were grown in YPD liquid medium supplemented with various soluble metals, with increasing concentrations of 0.1, 0.25, 0.5, 0.75, and 1 mM for mercury solution and of 10, 25, 50, 75, 100, 125, 150, 175, 200, 225, 250, 275, and 300 mM for the other heavy metal solutions. The inoculated flasks were incubated at 28 °C for 72 h. Non-metal supplemented liquid media were also inoculated and incubated to act as control. The yeast growth was measured using spectrophotometry by determining their optical density at 600 nm. The minimum inhibitory concentration (MIC) was defined as the lowest concentration of the heavy metal at which complete inhibition of visible growth of the yeast isolate was observed (Rossbach et al. 2000).
Effect of lead on growth and cell morphology of the metal-resistant yeast strains
The selected metal-resistant yeast strains were cultivated in 50 ml of YPD liquid medium adjusted to pH 6.5, non-supplemented (control) or supplemented with increasing concentrations (by a factor of two) of lead (31.25, 62.5, 125 ppm). The cultures were then grown at 28 °C with continuous shaking on a rotary shaker (150 rpm). Cell growth was determined spectrophotometrically by measuring the optical density of the culture broth at 600 nm after 24, 48, and 72 h. Following incubation for 72 h, yeast cells were collected and examined under optical microscope. The measurements of the cell cross-sectional area (the length and the width) were performed based on the morphological evaluations of 50 yeast cells and shape coefficient (ratio between length and width), which can determine the spherical shape of the cells when it equals 1 (Kieliszek et al. 2016).
Evaluation of lead removal capacity by actively growing yeast cells
After 72 h of yeast culture in shaking conditions (150 rpm) at 28 °C, aliquots of wet cells were obtained through centrifugation at 10,000 g for 15 min. All cell samples were washed twice with distilled de-ionized water before being contacted with the metal-bearing solutions. The effect of biomass concentration on the elimination of various concentrations of lead prepared from Pb(NO3)2 compound was studied. Briefly, suitable aliquots of live biomass (0.6, 1, and 1.5 g) were added in 250-ml conical flasks containing 100 ml of lead solution with known initial metal concentration (31.25, 62.5, and 125 ppm) and pH 6.5 and incubated for 24 h at room temperature. Control flasks without yeast biomass were also maintained for each concentration of lead solution. The evaluation of the residual lead concentration was carried out after centrifugation at 10,000 g for 5 min and analysis of the supernatant from each sample using atomic absorption spectrometry.
The biosorption efficiency (E (%)) was determined according to the following formula (Xin et al. 2012):
The metal uptake value (q) was calculated using the following equation (Salinas et al. 2000):
where V is the volume of metal solution (100 ml), Ci and Cf are the initial and final concentrations of metal, respectively (mg/l), and m is the mass of yeasts (g).
Statistical analysis
The different data obtained in the present study were statistically processed using the SPSS statistical computer software (version 23.0). Mean values were analyzed by two-way analysis of variance (ANOVA) and generalized linear model (GLM). The Tukey test was also performed to test the statistical level of significance (p < 0.05).
Results
Physico-chemical characteristics of the lake water
As shown in Table 1, the water sampled from Dayet Oum Ghellaz Lake was characterized by a slightly basic pH and high COD and BOD5 levels. Accordingly, the ratio COD/BOD5 was superior than 3, and water substances were hardly biodegradable (Ammar and Ueno, 1999). The level of electrical conductivity was elevated, which is somehow resulted from the high chloride concentrations. The amount of total phosphorus in water was relatively high. On the other hand, the results indicate significant contamination by lead, iron, and cadmium (Table 1).
Isolation and molecular characterization of heavy metal-resistant yeasts
A total of seven heavy metal-resistant yeast strains were isolated from water samples of Dayet Oum Ghellaz Lake named as WO1, WO2, WO3, WO4, WO6, CO5, and RO7 belonging to three species of three yeast genera (Table 2). RO7 was the only yeast species which developed intense red colonies when grown at 28 °C on plated solid media.
The BLAST analysis of the D1/D2 domain of the 26S rDNA gene belonging to the seven studied yeast strains revealed very high homologies between the WO1–WO6, CO5, and RO7 sequences and those of Wickerhamomyces anomalus, Clavispora lusitaniae, and Rhodotorula mucilaginosa, respectively, deposited at GenBank (Table 2). Wickerhamomyces anomalus was present as the most abundant (WO1–WO6) species in the lake water. The phylogenetic analysis of the studied sequences strongly supported also the affiliation of the seven yeast strain sequences to three clusters representing each of the pre-cited species with significant bootstrap or posterior probability values. Moreover, two major clades were highlighted corresponding to the ascomycetous yeasts where the two minor clades of Wickerhamomyces anomalus and Clavispora lusitaniae strains belong and the second major clade was represented by basidiomycetous yeasts and enclosed Rhodotorula mucilaginosa strain studied in the present work (Fig. 1, Table 2).
Phylogenetic tree derived from maximum likelihood analysis of the D1/D2 domain of 26S rDNA, showing the taxonomic position of the seven studied yeast species (indicated by filled circles). Schizosaccharomyces pombe UCDFST 40–277 (MH595199) was used as an outgroup. Bootstrap values (%) over 50% based on 1000 replication are given at nodes. The scale bar represents 0.05 substitutions per nucleotide position
Halotolerance of the yeasts
All the yeast strains exhibited high halotolerance as they were able to grow in the presence of 10–15% of NaCl (Table 3), although they did not require salts for their physiological activities. These results suggest that all the studied yeast strains have superior osmotic tolerance.
Heavy metal resistance and minimum inhibitory concentration (MIC)
The results of the present study showed the ability of seven yeast strains belonging to the species of Wickerhamomyces anomalus, Clavispora lusitaniae, and Rhodotorula mucilaginosa to resist and remove several heavy metals which may constitute a potential environmental pollutant.
The diameter of the inhibition zone differed significantly according to the yeast strain, the heavy metal type, and metal concentration (Table 3). In the present study, the MICs of the six studied heavy metal strains were between 10 and 300 mM (Table 4). The cadmium MIC ranged from 10 to 150 mM and the chromium MIC was between 10 and 75 mM. The zinc and iron MIC values reached 300 mM. The minimum inhibitory concentration of copper was between 50 and 250 mM. The seven yeast strains exhibited considerable MIC values of lead (25–200 mM). However, mercury was the most toxic metal for yeast strains with MIC between 0.1 and 0.5 mM (Table 4). Finally, W. anomalus WO2 and R. mucilaginosa RO7 strains displaying the highest MIC values were selected for lead removal assays.
Effect of lead on cell growth and morphology of the selected metal-resistant yeast
The growth rate of the selected yeast isolates exposed to different increasing concentrations of lead was good until 24 h of incubation and slightly decreased after 24 h and 48 h compared with control (without metal amendment) (Fig. 2). This result demonstrates the ability of the selected yeast strains to grow in the presence of lead.
The microscopic examination demonstrated also a significant increase in yeast cell size (length and width), following 72 h of yeast exposition to lead in the experimental media (Table 5; Fig. 3). In fact, in absence of lead, W. anomalus WO2 strain shows a cell size of 4.13 ± 1.23 × 3.18 ± 1.03 µm and a shape coefficient of 1.31 ± 0.17, giving to cells a slightly oval shape. However, in the presence of lead, the size increases progressively up to 6.34 ± 1.19 × 5.68 ± 1.26 µm with a shape coefficient of 1.14 ± 0.14. Thus, the increasing of the cell size induced form changes in yeast cells which adopted a spherical shape (Fig. 4a, b). R. mucilaginosa RO7 presents normally an average cell size of 4.35 ± 1.01 × 4.22 ± 0.92 µm with a shape coefficient of 1.03 ± 0.17 corresponding to the spherical form. After lead exposure, the cell size increased up to 6.02 ± 1.66 × 6.02 ± 1.66 µm, and the shape coefficient reduced slightly to 1 which really did not affect the spherical shape of cells (Fig. 4c, d).
Lead removal by living yeast cells
As shown in Fig. 5, the Pb uptake and the percentage of yeast cell removal efficiency was highly significant affected by the initial lead concentration and the amount of biomass. No significant difference was noticed in the effect of strains (Table 5).
Effect of biomass concentration of Wickerhamomyces anomalus WO2 and Rhodotorula mucilaginosa RO7 on lead removal efficiency (a, b) and lead uptake (c, d) in different concentrations of lead solution. Results are expressed as means ± SD (n = 3). Asterisks depict interaction between biomass and Pb concentrations at P < 0.0001 using generalized linear model. Uppercase letters indicate significant differences between biomass treatments and lowercase letters indicate significant differences among Pb concentrations within each biomass treatment using Tukey’s multiple comparison post hoc test (P < 0.05)
In this study, lead concentration of 31.25 ppm makes the purification activity significant in the presence of 1 g of biomass, with a high percentage of purification estimated at 85 ± 2% and 95.32 ± 1.06% for WO2 and RO7 strains, respectively. However, in the presence of 1.5 g of yeast biomass, the purification percentage becomes 80.5 ± 4.28%, and 84.5 ± 2% for WO2 and RO7 strains, respectively.
The maximum efficiency capacity of yeast strains in lead removal was established at high concentrations up to 125 ppm, with 1 5g of biomass for both strains which provided a remarkable purification activity (98.15 ± 0.90% for WO2; 97.046 ± 0.47% for RO7). Nevertheless, with 1 g of biomass, W. anomalus WO2 and R. mucilaginosa RO7 could efficiently remove 87.67% and 82.8% of lead, respectively (Fig. 5a, b).
The removal efficiency of lead by the two strains reached its maximum levels, 12.68 ± 0.91 mg/g and 15.55 ± 0.72 mg/g for WO2 and RO7, respectively, under the lowest concentration of fresh biomass (0.6 g) and for the highest lead concentration (125 ppm) (Fig. 5c, d).
Discussion
Oum Ghellaz Lake water was characterized by significant lead and cadmium contamination. Metal values were higher than maximum concentration foreseen in the environmental water quality guidelines. Furthermore, MI values exceeding 1 are a threshold of warning (Khazaal et al, 2019), indicating the worse quality of lake water. That lake was also characterized by high COD and BOD5. The ratio COD/BOD5 was superior to 3, and water substances were hardly biodegradable (Ammar and Ueno 1999). Based on the Interim National River Water Quality Standard (INRWQS) classification, the lake water is very polluted (in Akinbile et al. 2013). Extensive industrialization has brought about huge changes in the distribution of elements at the surface of the Earth. Metal-resistant microorganisms become dominant in habitats contaminated with relevant heavy metals (Rehman and Anjum 2011).
A total of seven heavy metal-resistant yeast strains were isolated from water samples of Dayet Oum Ghellaz Lake. Wickerhamomyces anomalus formerly known as, Hansenula anomala and Pichia anomala, this ascomycetous species is commonly reported from river water and lake (Coelho et al. 2010; Naito et al. 2019). In addition, W. anomalus is widely distributed in various ecological niches, suggesting thus a ubiquitous character of the yeast species. W. anomalus can survive in unfavorable conditions and grow in stressful environments, owing to its physiological versatility evidenced by the large number of metabolized carbon and nitrogen sources. Furthermore, this species presents interesting abilities in producing killer toxins and growing in a low active water level and osmotic stresses due to the presence of lactic acid, contributing in its overall competitiveness (Polonelli et al. 1983; Kurtzman and fell 1998; Heide-Marie et al. 2011; Restuccia et al. 2020). Clavispora lusitaniae is another ascomycetous yeast isolated from the studied lake water. This species is known as a cosmopolitan, saprobial, fermentative yeast whose ecological niche is still poorly elucidated. In fact, C. lusitaniae can be isolated from soil and water and from different plant substrates and hosts (de Almeida 2005; Coelho et al. 2010; Pérez-Brito et al. 2015). In the present work, we signaled the presence of Rhodotorula mucilaginosa, the red yeast species reported as a frequently occurring yeast species in several aquatic environments (Libkind et al. 2003; 2004; D’Elia et al. 2009; Silva-Bedoya et al. 2014). Moreover, this carotenogenic yeast is considered to be ubiquitous due to its worldwide distribution in terrestrial, freshwater, and marine habitats and to its ability to colonize a large variety of substrates (Libkind et al. 2008). The synthesis of carotenoids by these colored yeast species may represent an interesting issue for biotechnological studies on these microorganisms as a potential source of carotenoid pigment production (Tkáčová et al. 2015; Zhao et al. 2019; Garcia-Cortes et al. 2021).
The investigation of halotolerance property showed that all the yeast strains were salt-tolerant. This type of adaptation has received great attention from many researchers interested in studying genes of biotechnological importance, in order to improve the halotolerance of industrially important yeasts. Previous studies have reported that salt stress-tolerant yeast cells have generally a negatively charged molecules in the exopolymeric layer or uronic acids, which are directly proportional to the heavy metal chelation (Cho and Kim 2003).
The diameter of the heavy metal inhibition zone differed significantly according to the yeast strain and the heavy metal type. Similar results were obtained by Balsalobre et al. (2003) who reported that the metal tolerance and the uptake capacity are dependent on the ionic metal type and the yeast species. Moreover, our findings revealed that the seven studied strains displayed tolerance thresholds for heavy metals higher than those observed in many yeast strains isolated from metal-polluted aquatic or terrestrial environments (Muñoz et al. 2012; Oyetibo et al. 2014). Several studies have shown that the yeasts isolated from heavy metal-contaminated sites exhibit a marked adaptation mechanism of resistance against stress conditions due to the selective effect of metals (Ramirez-Ramirez et al. 2004; Lopez-Archilla et al. 2004; Srivastava and Thakur 2006). The cadmium MIC indicated a high level of yeast tolerance to heavy metals. The studied Rhodotorula mucilaginosa strain was found to be more highly resistant than other previously reported yeasts such as Candida tropicalis isolated from industrial wastewater with a cadmium MIC of 2.8 mg/l (Rehman and Anjum 2010). However, the Rhodotorula mucilaginosa AN5 strain isolated from Antarctic sea ice remains much more resistant to cadmium with a 1000 mM MIC (Kan et al. 2018). The chromium MIC values recorded in the present study are in accordance with those obtained for three yeast strains isolated from tannery sediment of mining site (30, 50, and 60 mM) (Villegas et al. 2008). Nevertheless, these MIC values remain much higher than that found in yeast isolated from industrial wastewater in Pakistan with a maximum of 2 mg/l (Rehman and Anjum 2010). The chromium tolerance observed in the studied Wickerhamomyces anomalus strains was also reported earlier in another strain of the same species isolated from a site receiving textile dye effluents and which could resist up to 50 mM of chromium and was able to reduce this metal from the state hexavalent (Cr (VI)) to trivalent state (Cr (III)) (Fernández et al. 2013). Thus, the Wickerhamomyces anomalus strains WO3, WO4, and WO6 displaying a considerable MIC (75 mM) could be a promising candidate in the bioremediation of chromium-contaminated waters. The zinc and iron values of MIC reached in the present work 300 mM and were significantly lower than those of copper. Previous studies have also demonstrated that the tolerance of yeast strains to Zn is higher than that for Cu (Vadkertiova and Slavikova 2006; Singh et al. 2013). The tolerance capacity of the studied strains to Zn is lower than that obtained in 53% of the yeast strains isolated by García-Béjar et al. (2020), which reaches a threshold of 100 mg/l. Despite the essentiality of zinc and iron for living organisms including yeasts, these metals can be nonetheless strongly harmful for microorganisms at high concentrations (Askwith et al. 1996; Balsalobre et al. 2003).
It is noteworthy that all the studied yeast strains exhibited higher tolerance to copper than many earlier described yeasts isolated from deep waters (maximum MIC of 1400 mg/l) (Singh et al. 2013) or industrial sewage (maximum MIC of 20 mM) (Irawati et al. 2017). However, some Cryptococcus sp. (Abe et al. 2001) and Rhodotorula mucilaginosa (Kan et al. 2018) species seem to display similar copper MIC values to those observed in the present investigation. Furthermore, the seven yeast strains exhibited considerable MIC values (25–200 mM) for lead metal which were much superior than those observed in similar studies (Shakoori et al.2005; Chatterjee et al. 2011; Singh et al. 2013). The Rhodotorula mucilaginosa RO7 tolerance threshold remains nevertheless lower than that obtained in a different strain of the same species, which was endowed with an interesting capacity to survive until 500 mM of lead (Kan et al. 2018). It is important to notice that mercury was the most toxic metal for the studied yeast strains. According to Oyetibo et al. (2014), the autochthonous yeast strains of polluted estuary water must have molecular alterations to evolve the high mercury resistance. The high toxicity of mercury on yeast can inhibit the enzymatic activity of enzyme catabolic metabolism and lead consequently to cessation of respiratory activities and rapid depletion of ATP (Brunker 1976; Oyetibo et al. 2014).
Our findings demonstrate also the ability of two autochthonous yeast strains R. mucilaginosa RO7 and Wickerhamomyces anomalus WO2 to grow in the presence of lead. R. mucilaginosa is a yeast species known by its ability to remove lead (Jiang et al. 2015; Li et al. 2019). Furthermore, similar properties with high Pb2 + adsorption capacity were reported for W. anomalus from China (Li and He, 2020). Exposition to lead induced a remarkable change in the size and form of yeast cells. These results are in accordance with several earlier studies which demonstrated that the presence of lead in culture media can affect yeast cells and induce changes in their size and morphology (Bussche and Soares 2011; Sousa et al. 2014; Li et al. 2019). The cytotoxic effects of lead involve induction of apoptotic cell death in order to maintain the integrity of their plasma membrane, which was reported as a non-immediate target for lead toxicity (Van der Heggen et al. 2010; Bussche and Soares 2011). Lead can also be accumulated in the vacuoles, reducing the metal toxicity and cell swellings (Sousa et al. 2014). Other studies have proved that lead toxicity can even reach nucleic acids since it is able to reduce the ratio DNA/RNA and induce DNA damage (Yuan and Tang 1999; Chen and Wang 2007).
The present results also exhibited that the Pb uptake and the percentage of the yeast cell removal efficiency were highly significant and were affected by the initial lead concentration and the amount of biomass. In fact, at lead concentration of 31.25 ppm, the purification activity was more significant at low yeast biomass concentration than at high biomass concentration. These results are in accordance with those obtained by several authors (Ferraz and Teixeira 1999; Cho et al. 2004; Farhan and Khadom 2015) who reported that the purification activity of Pb decreases when the amount of yeast strains increases. This could be explained by the increased electrostatic interactions at high biomass concentrations, inhibiting the metal biosorption, and the mass transfer limitations within yeast cells (Ferraz and Teixeira 1999; Cho et al. 2004). In contrast, the data from the investigations made with 125 ppm of lead concentration were contradictory with those obtained in lower lead concentration. Indeed, a direct relationship between the biomass concentration tested and the purification rate was observed at high Pb concentration. This finding may be attributed to the available active binding sites of the biomass for the available sorbate ions (Dahiya et al. 2008). It is noteworthy that the percentage of lead removal obtained in the present study is higher than those reported for other yeast strains such as R. mucilaginosa (32.5%) or Saccharomyces cerevisiae (52.94%, 79.9%) (Skountzou et al. 2003; Zhang et al. 2009; Li et al. 2019).
On the other hand, the removal efficiency of lead by the two strains reached its maximum levels at the highest lead concentration and under the lowest concentration of fresh biomass. These results confirm one more time the reverse relationship observed between biomass concentration and metal removal activity.
Conclusion
Based on the current research, we conclude that the seven yeast strains isolated from lake water polluted by lead and cadmium exhibited remarkable halotolerance and resistance to several heavy metals with MICs ranging between 10 to 300 mM for copper, zinc, lead, cadmium, chromium, and iron and between 0.1 to 0.5 mM for mercury. The two strains W. anomalus WO2 and R. mucilaginosa RO7 exhibited highly significant activities in lead removal, mostly at high lead concentration along with high biomass concentration. These results are very promising as a starting point for a potential application of these metal-resistant yeast strains in bioremediation of industrial effluent and the treatment of heavy metal-containing wastewater.
References
Abe F, Miura T, Nagahama T, Inoue A, Usami R, Horikoshi K (2001) Isolation of a highly copper-tolerant yeast, Cryptococcus sp., from the Japan Trench and the induction of superoxide dismutase activity by Cu2+. Biotechnol Lett 23:2027–2034. https://doi.org/10.1023/A:1013739232093
Akinbile CO, Yusoff MS, Talib SHA, Hasan ZA, Haque AMM, Samsudin UB (2013) Qualitative analysis and classification of surface water in Bukit Merah reservoir in Malaysia. Water Sci Technol 13:1138–1145. https://doi.org/10.2166/ws.2013.104
Altschul SF, Madden TL, Schaffer AA, Zhang JH, Zhang Z, Miller W, Lipman DJ (1997) Gapped BLAST and PSI-BLAST: a new generation of protein database search programs. Nucleic Acids Res 25:3389–3402. https://doi.org/10.1093/nar/25.17.3389
Ammar E, Ueno S (1999) Connaissances de base pour la lutte contre la pollution des eaux usées. Association Japonaise pour le contrôle et la protection de l’environnement industriel (AJCPEI), Sfax, pp 55– 182.
Askwith CC, De Silva D, Kaplan J (1996) Molecular biology of iron acquisition in Saccharomyces cerevisiae. Mol Microbiol 20:27–34. https://doi.org/10.1111/j.1365-2958.1996.tb02485.x
Ayangbenro AS, Babalola OO (2017) A new strategy for heavy metal polluted environments: a review of microbial biosorbents. Int J Environ Res Public Health 14:1–16. https://doi.org/10.3390/ijerph14010094
Balsalobre L, De-Siloniz MI, Validerrama MJ, Benito T, Larrea MT, Peinado JM (2003) Occurrence of yeasts in municipal wastes and their behaviour in presence of cadmium copper and zinc. J Basic Microbiol 43:185–193. https://doi.org/10.1002/jobm.200390021
Bendjama A, Djabrib L, Chouchanea T, Boukari A, Tlili S (2014) La contamination métallique des eaux lacustres des zones humides du PNEK située au Nord-Est algérien. Actes de la conférence internationale sur l’énergétique appliquée et la pollution. Décembre 14–15. Constantine.
Benmalek Y, Fardeau ML (2016) Isolation and characterization of metal-resistant bacterial strain from wastewater and evaluation of its capacity in metal-ions removal using living and dry bacterial cell. Int J Environ Sci Technol 13:2153–2162. https://doi.org/10.1007/s13762-016-1048-6
Brunker RL (1976) Mercurial toxicity in yeast: evidence for catabolic pathway inhibition. Appl Environ Microbiol 32(4):498–504
Burgaud G, Coton M, Jacques N, Debaets S, Maciel NOP, Rosa CA, Gadanho M, Sampaio JP, Casaregola S (2016) Yamadazyma barbieri f.a. sp. nov., an ascomycetous anamorphic yeast isolated from a Mid-Atlantic Ridge hydrothermal site (2300 m) and marine coastal water. Int J Syst Evol Micr 66:3600–3606. https://doi.org/10.1099/ijsem.0.001239
Bussche JV, Soares EV (2011) Lead induces oxidative stress and phenotypic markers of apoptosis in Saccharomyces cerevisiae. Appl Microbiol Biotechnol 90:679–687. https://doi.org/10.1007/s00253-010-3056-7
Chatterjee S, Gupta D, Roy P, Chatterjee CN, Saha P, Dutta S (2011) Study of a lead tolerant yeast strain BUSCY1 (MTCC9315). Afr J Microbiol Res 5:5362–5372. https://doi.org/10.5897/AJMR11.853
Chen C, Wang JL (2007) Response of Saccharomyces cerevisiae to lead ion stress. Appl Microbiol Biotechnol 74:683–687. https://doi.org/10.1007/s00253-006-0678-x
Cho DH, Kim EY (2003) Characterization of Pb+2 bioadsorption from aqueous solution by Rhodotorula glutinis. Bioprocess Biosyst Eng 25:271–277. https://doi.org/10.1007/s00449-002-0315-8
Cho DH, Yoo MH, Kim EY (2004) Biosorption of lead (Pb2+) from aqueous solution by Rhodotorula aurantiaca. J Microbiol Biotechnol 14:250–255
Coelho MA, Almeida JMF, Martins IM, Jorge da Silva A, Sampaio JP (2010) The dynamics of the yeast community of the Tagus river estuary: testing the hypothesis of the multiple origins of estuarine yeasts. Antonie Van Leeuw 98:331–342. https://doi.org/10.1007/s10482-010-9445-1
Dahiya S, Tripathi RM, Hegde AG (2008) Biosorption of lead and copper from aqueous solutions by pretreated crab and arca shell biomass. Bioresour Technol 99(1):179–187. https://doi.org/10.1016/j.biortech.2006.11.011
D’Elia T, Veerapaneni R, Theraisnathan V, Rogers SO (2009) Isolation of fungi from Lake Vostok accretion ice. Mycologia 101:751–763. https://doi.org/10.3852/08-184
De Almeida JMGCF (2005) Yeasts community survey in the Tagus estuary. FEMS Microb Ecol 53(2):295–303. https://doi.org/10.1016/j.femsec.2005.01.006
El-Shahawi MS, Hamza A, Bashammakhb AS, Al-Saggaf WT (2010) An overview on the accumulation, distribution, transformations, toxicity and analytical methods for the monitoring of persistent organic pollutants. Talanta 80:1587–1597. https://doi.org/10.1016/j.talanta.2009.09.055
Farhan SN, Khadom AA (2015) Biosorption of heavy metals from aqueous solutions by Saccharomyces cerevisiae. Int J Ind Chem 6:119–130. https://doi.org/10.1007/s40090-015-0038-8
Fernández PM, Cabral ME, Delgado OD, Fariña JI, Figueroa LIC (2013) Textile dye polluted waters as an unusual source for selecting chromate-reducing yeasts through Cr (VI)-enriched microcosms. Int Biodeterior Biodegrad 79:28–35. https://doi.org/10.1016/j.ibiod.2013.01.009
Ferraz AI, Teixeira JA (1999) The use of flocculating brewer’s yeast for Cr (III) and Pb (II) removal from residual wastewaters. Bioprocess Eng 21:431–437. https://doi.org/10.1007/PL00009083
Gadd GM, Mowll JL, White C, Newby PJ (1986) Methods for assessment of heavy metal toxicity towards fungi and yeasts. Tox Assess 1:169–185. https://doi.org/10.1002/tox.2540010204
García-Béjar B, Arévalo-Villena M, Guisantes-Batan E, Rodríguez-Flores J, Briones A (2020) Study of the bioremediatory capacity of wild yeasts. Sci Rep 10:11265. https://doi.org/10.1038/s41598-020-68154-4
Garcia-Cortes A, Garcia-Vásquez JA, Aranguren Y, Ramirez-Castrillon M (2021) Pigment production improvement in Rhodotorula mucilaginosa AJB01 using design of experiments. Microorganisms 9:387. https://doi.org/10.3390/microorganisms9020387
Heide-Marie D, Moons MC, Huret S, Vrancken G, De Vuyst L (2011) Wickerhamomyces anomalus in the sourdough microbial ecosystem. Antonie Van Leeuw 99:63–73. https://doi.org/10.1007/s10482-010-9517-2
Hoffman CS, Winston F (1987) A ten-minute DNA preparation from yeast efficiently releases autonomous plasmids for transformaion of Escherichia coli. Gene 57(2–3):267–272
Irawati W, Parhusip AJN, Christian Yuwono ST (2017) The potential capability of bacteria and yeast strains isolated from Rungkut Industrial Sewage in Indonesia as a bioaccumulators and biosorbents of copper. Biodiversitas 18(3):971–977. https://doi.org/10.13057/biodiv/d180315
Jiang BH, Zhao Y, Zhao X, Hu XM, Li L (2015) Examination of Pb2+ bio-sorption onto Rhodotorula mucilaginosa using response surface methodology. Water Sci Technol 72:810–816. https://doi.org/10.2166/wst.2015.275
Kan GF, Wang XF, Jiang J, Zhang CS, Chi ML, Ju Y, Shi CJ (2018) Copper stress response in yeast Rhodotorula mucilaginosa AN5 isolated from sea ice. Antarctic Microbiology Open 1–18:e00657. https://doi.org/10.1002/mbo3.657
Khazaal SH, Al-Azawi KF, Eassa HA, Khasraghi AH, Alfatlawi WR, Al-Gebori AM (2019) Study the level of some heavy metals in water of Lake Habbaniyah in Al-Anbar-Iraq. Energy Procedia 157:68–74. https://doi.org/10.1016/j.egypro.2018.11.165
Kieliszek M, Błażejak S, Bzducha-Wróbel A, Kurcz A (2016) Effects of selenium on morphological changes in Candida utilis ATCC 9950 yeast cells. Biol Trace Elem Res 69:387–393. https://doi.org/10.1007/s12011-015-0415-3
Kimura M (1980) A simple method for estimating evolutionary rate of base substitutions through comparative studies of nucleotide sequences. J Mol Evol 16:111–120. https://doi.org/10.1007/BF01731581
Kumar S, Stecher G, Tamura K (2016) MEGA7: Molecular Evolutionary Genetics Analysis version 7.0 for bigger datasets. Mol Biol Evol 33:1870–1874. https://doi.org/10.1093/molbev/msw054
Kurtzman CP, Fell JW (1998) The yeasts, a taxonomic study. Elsevier Science Publishers, Amsterdam., p 1076
Lepp NW (2012) Effect of heavy metal pollution on plants. Metals in the environment, Pollution monitoring series, Applied Science Publishers, Department of Biology. Liverpool, United Kingdom. Liverpool Polytechnic
Li J, Jianga Z, Chena S, Wanga T, Jianga L, Wanga M, Sb W, Lia Z (2019) Biochemical changes of polysaccharides and proteins within EPS under Pb (II) stress in Rhodotorula mucilaginosa. Ecotoxicol Environ Saf 174:484–490. https://doi.org/10.1016/j.ecoenv.2019.03.004
Li L, He Y (2020) Adsorption characteristics and mechanism of Pb2+ by Wickerhamomyces anomalus QF-1-1, with high Pb2+ adsorption capacity. Shipin Kexue/food Science 41:152–158. https://doi.org/10.7506/spkx1002-6630-20191031-349
Libkind D, Brizzio S, Van Broock M (2004) Rhodotorula mucilaginosa, a carotenoid producing yeast strain from a Patagonian high-altitude lake. Folia Microbiol 49:19–25. https://doi.org/10.1007/bf02931640
Libkind D, Brizzio S, Ruffini A, Gadanho M, Van Broock M, Sampaio JP (2003) Molecular characterization of carotenogenic yeasts from aquatic environments in Patagonia, Argentina. Antonie Van Leeuw 84:313–322. https://doi.org/10.1023/A:1026058116545
Libkind D, Gadanho M, Broock MV, Sampaio JP (2008) Studies on the heterogeneity of the carotenogenic yeast Rhodotorula mucilaginosa from Patagonia, Argentina. J Basic Microbiol 48:93–98. https://doi.org/10.1002/jobm.200700257
Lopez-Archilla A, Gonzalez A, Terron M, Amils R (2004) Ecological study of the fungal populations of the acidic Tinto River in southwestern Spain. Can J Microbiol 50:923–934. https://doi.org/10.1139/w04-089
Mani D, Kumar C (2014) Biotechnological advances in bioremediation of heavy metals contaminated ecosystems: an overview with special reference to phytoremediation. Int J Environ Sci Technol 11:843–872. https://doi.org/10.1007/s13762-013-0299-8
Melgar MJ, Alonso J, Garcia MA (2007) Removal of toxic metals from aqueous solutions by fungal biomass of Agaricus macrosporus. Sci Total Environ 385:12–19. https://doi.org/10.1016/j.scitotenv.2007.07.011
Muñoz AJ, Ruiz E, Abriouel H, Gálvez A, Ezzouhri L, Lairini K, Espínola F (2012) Heavy metal tolerance of microorganisms isolated from wastewaters: identification and evaluation of its potential for biosorption. Chem Eng J 210:325–332. https://doi.org/10.1016/j.cej.2012.09.007
Naito Y, Okai M, Ishida M, Takashio M, Urano N (2019) Bioethanol production from molasses by yeasts with stress-tolerance isolated from aquatic environments in Japan. Adv Microbiol 9:1000–1011. https://doi.org/10.4236/aim.2019.912065
O’Donnell K (1993) Fusarium and its near relatives. In The fungal holomorph: mitotic, meiotic and pleomorphic speciation in fungal systematics. Edited by D. R. Reynolds & J. W. Taylor. Wallingford, UK: CAB International. pp. 225–233.
Oyetibo GO, Ishola S, Ikeda-Ohtsubo W, Miyauchi K, Ilori MO, Endo G (2014) Mercury bioremoval by Yarrowia strains isolated from sediments of mercury-polluted estuarine water. Appl Microbiol Biotechnol 99:3651–3657. https://doi.org/10.1007/s00253-014-6279-1
Parameswari E, Lakshmanan A, Thilagavathi T (2010) Biosorption and metal tolerance potential filamentous fungi isolated from metal polluted ecosystem. Elec J Env Agricult Food Chem 9:664–671
Pérez-Brito D, Magaña-Alvarez A, Lappe-Oliveras P, Cortes-Velazquez A, Torres-Calzada C, Herrera-Suarez T, Larqué-Saavedra A, Tapia-Tussell R (2015) Genetic diversity of Clavispora lusitaniae isolated from Agave fourcroydes Lem, as revealed by DNA fingerprinting. J Microbiol 53:14–20. https://doi.org/10.1007/s12275-015-4373-4
Polonelli L, Archibusacci C, Sestito M, Morace G (1983) Killer system: a simple method for differentiating Candida albicans strains. J Clin Microbiol 17: 774–780. https://doi.org/10.1128/JCM.17.5.774-780.1983
Ramirez-Ramirez R, Calvo-Mendez C, Avila-Rodriguez M, Lappe P, Ulloa M, Vazquez-Juarez R, Gutierrez Corono F (2004) Cr (VI) reduction in a chromate-resistant strain of Candida maltosa isolated from the leather industry. Antonie Van Leeuwenhoek 85:63–68. https://doi.org/10.1023/B:ANTO.0000020151.22858.7f
Rehman A, Anjum MS (2010) Cadmium uptake by yeast, Candida tropicalis, isolated from industrial effluents and its potential use in wastewater clean-up operations. Water Air Soil Pollut 205:149–159. https://doi.org/10.1007/s11270-009-0062-4
Rehman A, Anjum MS (2011) Multiple metal tolerance and biosorption of cadmium by Candida tropicalis isolated from industrial effluents: glutathione as detoxifying agent. Environ Monit Assess 174:585–595. https://doi.org/10.1007/s10661-010-1480-x
Restuccia C, Lombardo M, Scavo A, Mauromicale G, Cirvilleri G (2020) Combined application of antagonistic Wickerhamomyces anomalus BS91 strain and Cynara cardunculus L. leaf extracts for the control of postharvest decay of citrus fruit. Food Microbiology 92: 103583. https://doi.org/10.1016/j.fm.2020.103583
Rigoletto M, Calza P, Gaggero E, Malandrino M, Fabbri D (2020) Bioremediation methods for the recovery of lead-contaminated soils: a review. Appl Sci 10:3528. https://doi.org/10.3390/app10103528
Rossbach S, Wilson T, Kukuk M, Carty H (2000) Elevated zinc induces siderophore biosynthesis genes and zntA-like gene in Pseudomonas fluorescens. FEMS Microbiol Lett 191:61–70. https://doi.org/10.1111/j.1574-6968.2000.tb09320.x
Salinas E, De Orellano ME, Rezza I, Martinez L, Marchesvky E, De Tosetti MS (2000) Removal of cadmium and lead from dilute aqueous solutions by Rhodotorula rubra. Bioresour Technol 72:107–112. https://doi.org/10.1016/S0960-8524(99)00111-X
Shakoori AR, Huma ZI, Dar N, Shahid SA (2005) Lead resistant yeast from industrial waste water capable of decontaminating it of heavy metals. Pak J Zool 37:1–11
Silva-Bedoya LM, Ramírez-Castrillón M, Osorio-Cadavid E (2014) Yeast diversity associated to sediments and water from two Colombian artificial lakes. Braz J Microbiol 45:135–142. https://doi.org/10.1590/S1517-83822014005000035
Singh P, Raghukumar C, Parvatkar RR, Mascarenhas-Pereira MBL (2013) Heavy metal tolerance in the psychrotolerant Cryptococcus sp. isolated from deep-sea sediments of the Central Indian Basin. Yeast 30:93–101. https://doi.org/10.1002/yea.2943
Skountzou P, Soupioni M, Bekatorou A, Kanellaki M, Koutinas A, Marchant R, Banat I (2003) Lead (II) uptake during baker’s yeast production by aerobic fermentation of molasses. Process Biochem 38:1479–1482. https://doi.org/10.1016/S0032-9592(03)00023-2
Sousa CA, Perez RR, Soares EV (2014) Saccharomyces cerevisiae mutants affected in vacuole assembly or vacuolar H+-ATPase are hypersensitive to lead (Pb) toxicity. Curr Microbiol 68:113–119. https://doi.org/10.1007/s00284-013-0438-y
Srivastava S, Thakur IS (2006) Isolation and process parameter optimization of Aspergillus sp. for removal of chromium from tannery effluent. Bioresour Technol 97:1167–1173. https://doi.org/10.1016/j.biortech.2005.05.012
Sun GL, Reynolds EE, Belcher AM (2020) Using yeast to sustainably remediate and extract heavy metals from waste waters. Nat Sustain 3:303–311. https://doi.org/10.1038/s41893-020-0478-9
Tamasi G, Cini R (2004) Heavy metals in drinking waters from Mount Amiata. Possible risks from arsenic for public health in the province of Siena. Sci Total Environ 327:41–51. https://doi.org/10.1016/j.scitotenv.2003.10.011
Tarekegn MM, Salilih FZ, IshetuAI, (2020) Microbes used as a tool for bioremediation of heavy metal from the environment. Cognent Food Agri 6:1783174. https://doi.org/10.1080/01490451.2020.1817198
Tkáčová J, Furdíková K, Klempová T, Ďurčanská K, Čertík M (2015) Screening of carotenoid-producing Rhodotorula strains isolated from natural sources. Acta Chim Slov 8:34–38. https://doi.org/10.1515/acs-2015-0007
Vadkertiova R, Slavikova E (2006) Metal tolerance of yeasts isolated from water, soil and plant environments. J Basic Microbiol 46:145–152. https://doi.org/10.1002/jobm.200510609
Van der Heggen M, Martins S, Flores G, Soares EV (2010) Lead toxicity in Saccharomyces cerevisiae. Appl Microbiol Biotechnol 88:1355–1361. https://doi.org/10.1007/s00253-010-2799-5
Villegas L, Amoroso MJ, Figueroa LIC (2004) Selection of tolerant heavy metal yeasts from different polluted sites. In: Spencer JFT, Spencer ALR (eds) Methods in biotechnology. Environmental biology, methods in protocols. Humana Press Inc Totowa pp 16: 249–256.
Villegas L, Fernandez PM, Amoroso MJ, de Figueroa LIC (2008) Chromate removal by yeasts isolated from sediments of a tanning factory and a mine site in Argentina. Biometals 21:591–600. https://doi.org/10.1007/s10534-008-9145-8
Xin X, Wei Q, Yang J, Yan L, Feng R, Chen G, Du B, Li H (2012) Highly efficient removal of heavy metal ions by amine-functionalized mesoporous Fe3O4 nanoparticles. Chem Eng J 184:132–140. https://doi.org/10.1016/j.cej.2012.01.016
Yuan XF, Tang CC (1999) DNA damage and repair in yeast (Saccharomyces cerevisiae) cells exposed to lead. J. Environ. Sci Health Part A-Toxic/hazard Subst Environ Eng 34:1117–1128. https://doi.org/10.1080/10934529909376885
Zhang Y, Fan C, Meng Q, Diao Z, Dong L, Peng X, Ma S, Zhou Q (2009) Biosorption of Pb2+ by Saccharomyces cerevisiae in static and dynamic adsorption tests. Bull Environ Contam Toxicol 83:708–712. https://doi.org/10.1007/s00128-009-9847-9
Zhao Y, Guo L, Xia Y, Zhuang X, Chu W (2019) Isolation, identification of carotenoid-producing Rhodotorula sp. from marine environment and optimization for carotenoid production. Mar Drugs 17,161. https://doi.org/10.3390/md17030161
Acknowledgements
The authors acknowledge the financial support of the Algerian General Directorate of Scientific Research and Technological Development (DGRSDT) and the Algerian Ministry of Higher Education and Scientific Research (MESRS).
Author information
Authors and Affiliations
Corresponding author
Ethics declarations
Ethics approval
This article does not contain any studies with human participants or animals performed by any of the authors.
Conflict of interest
The authors declare no competing interests.
Additional information
Publisher's note
Springer Nature remains neutral with regard to jurisdictional claims in published maps and institutional affiliations.
Rights and permissions
About this article
Cite this article
Aibeche, C., Selami, N., Zitouni-Haouar, F.EH. et al. Bioremediation potential and lead removal capacity of heavy metal-tolerant yeasts isolated from Dayet Oum Ghellaz Lake water (northwest of Algeria). Int Microbiol 25, 61–73 (2022). https://doi.org/10.1007/s10123-021-00191-z
Received:
Revised:
Accepted:
Published:
Issue Date:
DOI: https://doi.org/10.1007/s10123-021-00191-z